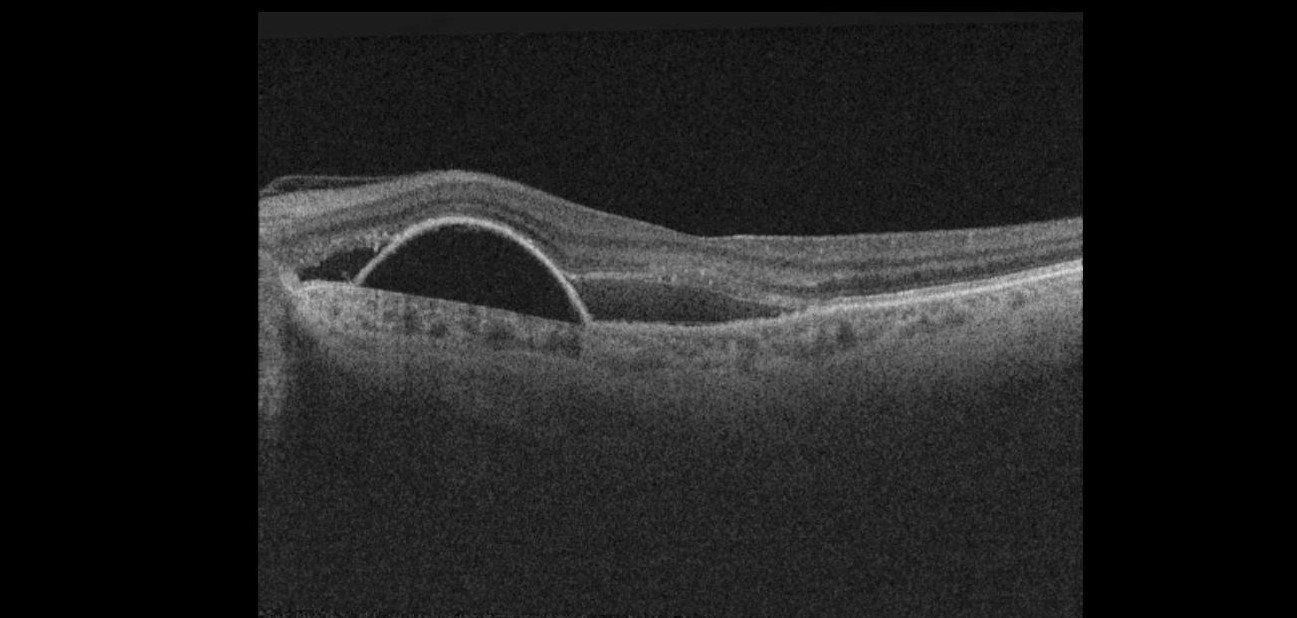
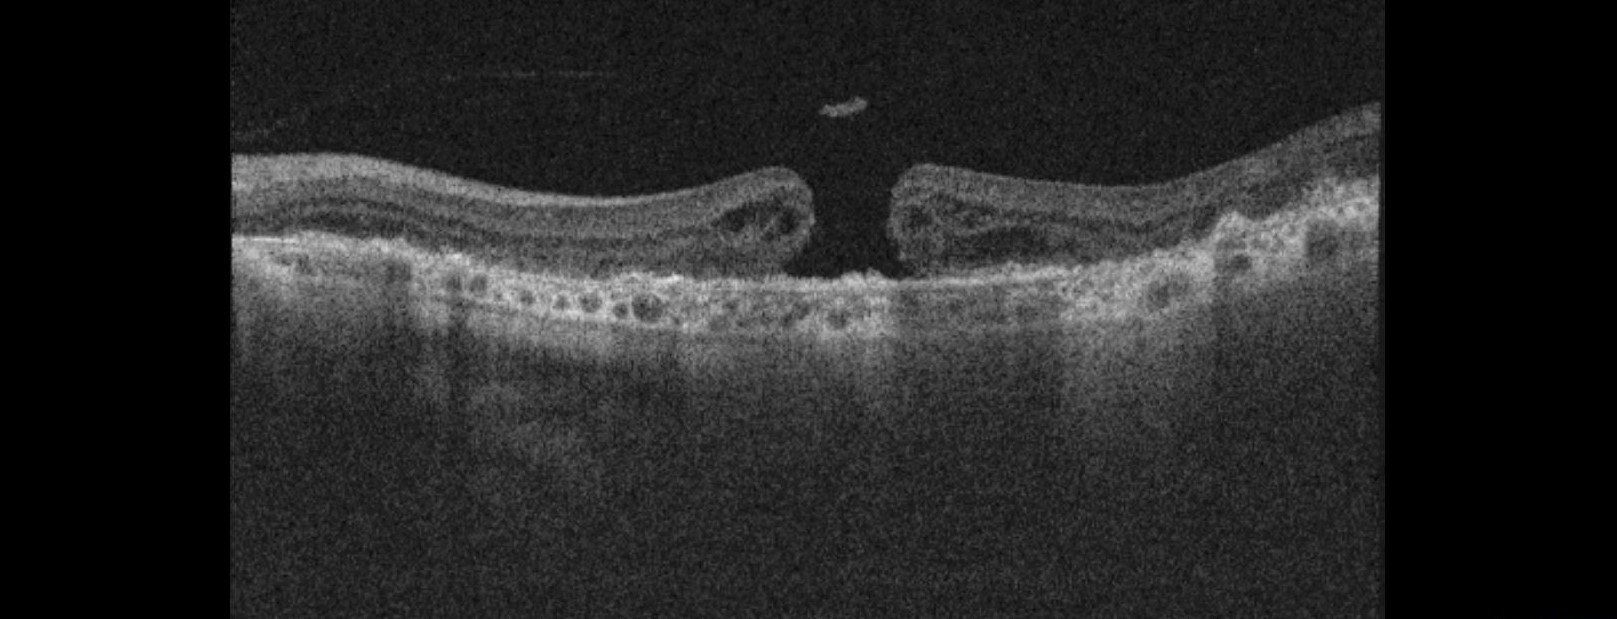
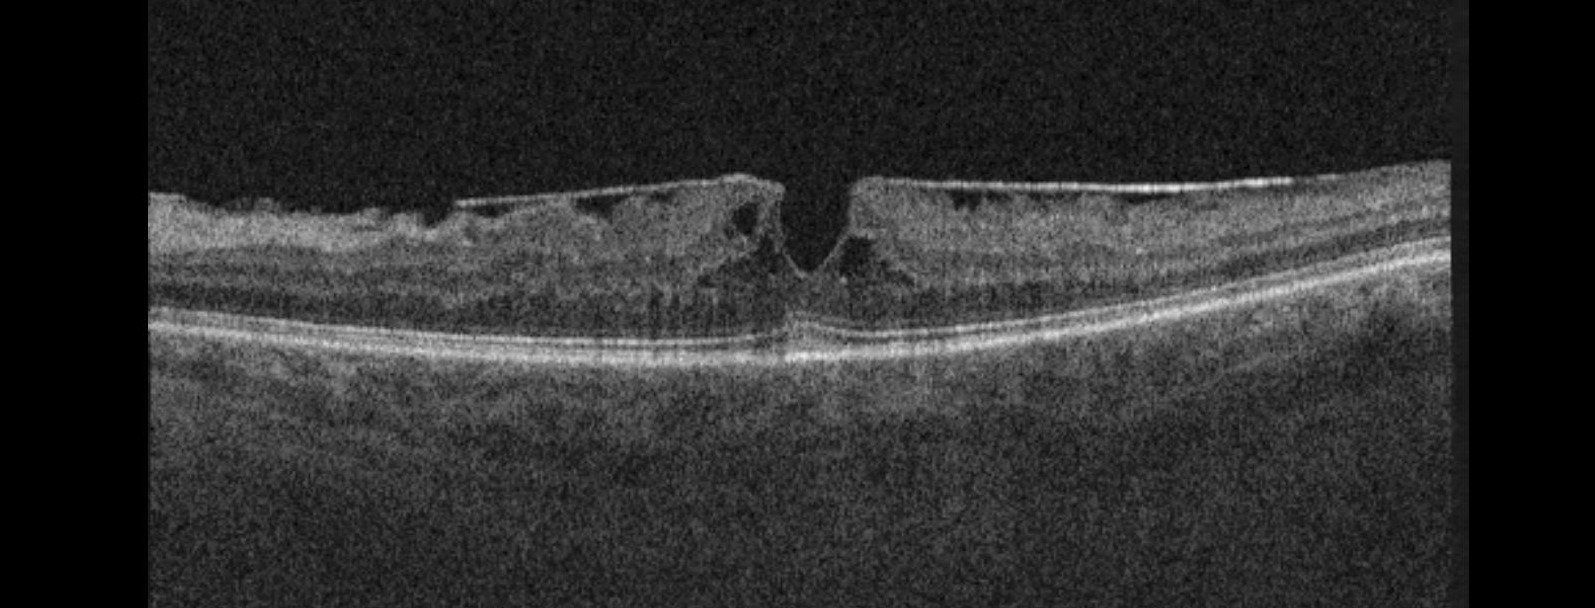
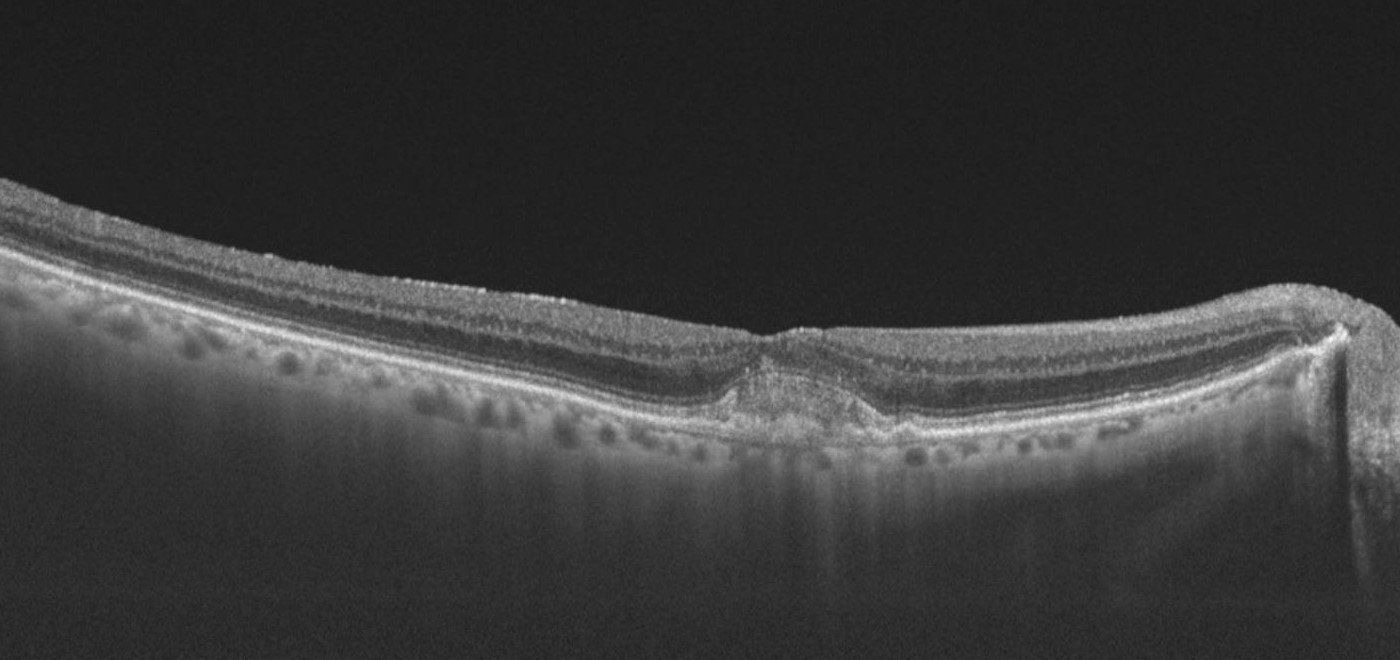

OCULAR COHERENCE TOMOGRAPHY (OCT)
is a highly advanced scanning technique that takes 3D scans of the back of the eye, right down to individual cell layers. Regular OCT scans help us to screen your eyes for potentially serious conditions such as glaucoma, diabetes and age-related macular degeneration.
Early detection will always lead to better outcomes, which is why screening checks for conditions such as breast, bowel and prostate cancer are becoming increasingly important. OCT scans allow us to screen your eyes in a similar fashion. Detecting changes in their infancy, puts us in an improved position to deal with them more effectively, thereby ensuring your eyes are as healthy as they can be going forwards.
OCT scans give us an invaluable record of the health and condition of your eyes. It is non invasive and takes only a few moments. OCT scans are included as part of your
First Contact Care Plan and are carried out during your examination. The scans can be assessed immediately and the results discussed with you during your appointment.
Below are some real life examples of scans which have been taken in our practice to diagnose conditions.....
Wet age-related macular degeneration (AMD)
- This occurs when there is a buildup of fluid in the underlying layers of the macula, secondary to degeneration of the cells that process light.
Full thickness macular hole -This is a defect that affects all the layers at the macula. One cause of this is when the jelly at the back of the eye pulls away, but ‘does not let go’ causing the retina to tear and leaves a hole.
Epiretinal membrane -This is where the layer on the surface of the retina ‘wrinkles’. Patients may experience no symptoms at all, blurring or even distortion in their vision.
Best's Disease -
This is a genetic condition caused by the inability of the cells at the macula to regenerate properly. The result is a buildup of yellow pigment at the macula.